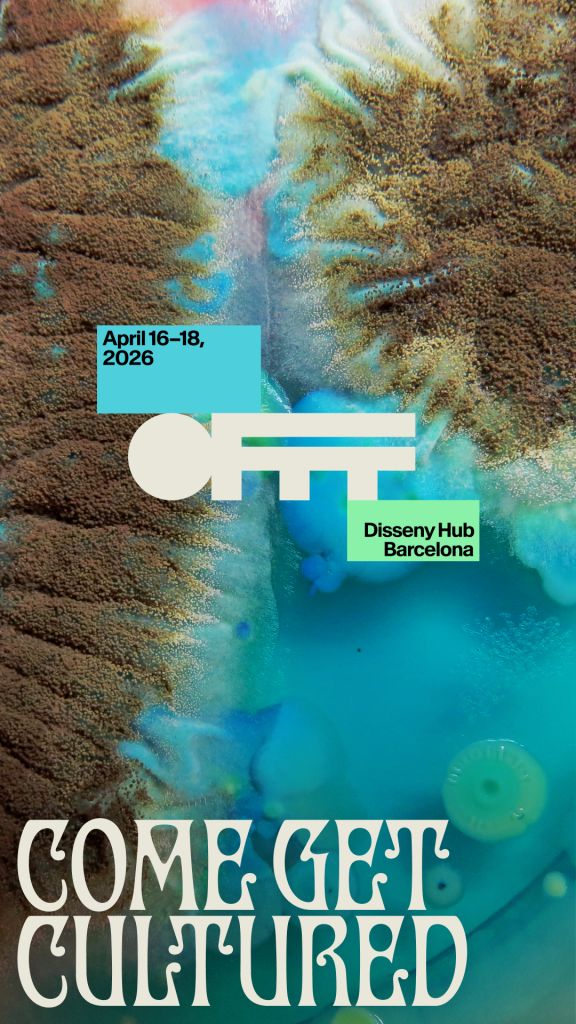

In a world that sometimes feels like it’s running on low battery—politically, socially, algorithmically—design conferences might seem like an indulgence. But step inside OFFF Barcelona, and you’re reminded why gathering in real life still matters.
From April 16–18, 2026, OFFF returns to the halls of Disseny Hub Barcelona for its 26th edition. Since its founding in 2001, the festival has served as a meeting point for the most innovative and generous minds in creativity, art, and digital design. The goal hasn’t changed: bring people together, pull back the curtain, and let audiences see how the work actually gets made.
Cultured
This year’s visual campaign, developed in collaboration with Uncommon Creative Studio, does more than brand the festival—it frames the conversation. Titled Cultured, the concept zooms in on a truth most of us know instinctively: creativity is a steady accumulation of references, lectures, screenshots, dog-eared books, overheard comments, half-built files and half-formed thoughts. In other words, it’s communal.
The message is straightforward: our industry is what we make it. Design is what we make it. Culture itself takes form under the right conditions—through collaboration, shared agency, and intentional growth.
It’s also a call to action. Not a passive theme, but an open invitation. Show up. Participate. Add your perspective to the pile. Because creativity isn’t culture authored by a select few—it’s culture built collectively, influenced and refined by many voices at once.
A Lineup That Crosses Borders (and Disciplines)
OFFF has always thrived on range. This year’s lineup spans agencies, studios, solo artists, strategists, animators, and architects—people who don’t just set trends, but explore and investigate them.
You’ll find voices from major studios like Stockholm Design Lab (with Björn Kusoffsky), teamLab, Moment Factory, Volvox Labs, Foster+Partners, and CODA. Add to that a global roster of photographers, visual artists, 3D pioneers, art directors, and branding minds—each bringing their own creative context and lived experience.
However, what makes OFFF different isn’t just the prestigious speakers, it’s proximity to their humanity. You don’t just see the final work projected on a massive screen—you hear about the false starts, the rejected directions, the uncomfortable pivots. You get the messy middle.
And then you get the hallway conversations.
The Hallway Is the Point
Design conferences aren’t just about talks. They’re also about the in-between moments. The coffee line debates, the accidental introductions, the shared eye-roll over a slide that didn’t quite land, and the communal laughter when a great joke does.
In fractured times, there’s something radical about gathering in the same physical space. You sit next to someone whose politics might not mirror yours. Whose aesthetic definitely doesn’t. Whose career path took a completely different route. And yet, you’re all there for the same reason: to understand how ideas become form.
A few years ago, PRINT’s co-publisher and I had the chance to attend OFFF, and we quickly realized it’s far more than a series of talks. It feels like a temporary city built by designers who have consciously chosen to gather. Being there was a powerful reminder that creativity is never created in isolation. Even the most distinctive voice is shaped by community—by mentors, competitors, collaborators, critics, and the places we inhabit. When hundreds—sometimes thousands—of those voices come together in one space, the result isn’t just the next big trend. It’s something more meaningful: a real, ongoing conversation.
Barcelona as Backdrop
And, yeah, it doesn’t hurt that this all unfolds in Barcelona—a city where design, architecture, and public life are tightly interwoven. With its upcoming designation as UNESCO World Capital of Architecture 2026, OFFF’s inclusion of leading architecture studios feels especially timely. Including architectural thinkers alongside branding strategists and immersive artists, the programming underscores a shared truth: every discipline is shaping the same cultural landscape. Whether you’re designing a logo, an installation, or a building façade, you’re participating in a similar creative ecosystem.
Why We Still Need This
OFFF Barcelona has been doing this for 26 years. That kind of longevity isn’t accidental. It’s built on the belief that creativity flourishes when people gather, share, challenge, and celebrate one another’s work. In divided times, choosing to convene is a statement. It says we still believe in dialogue. In process. In the power of seeing how something is made—and who made it. It reaffirms what this year’s theme drives home: the industry isn’t something that just happens to us. Design is what we make it. Culture is what we make it. And for three days in April, inside Disseny Hub Barcelona, it will be made—together.
Find out more about OFFF Barcelona and register to attend.
The post OFFF Barcelona: Why We Still Show Up appeared first on PRINT Magazine.